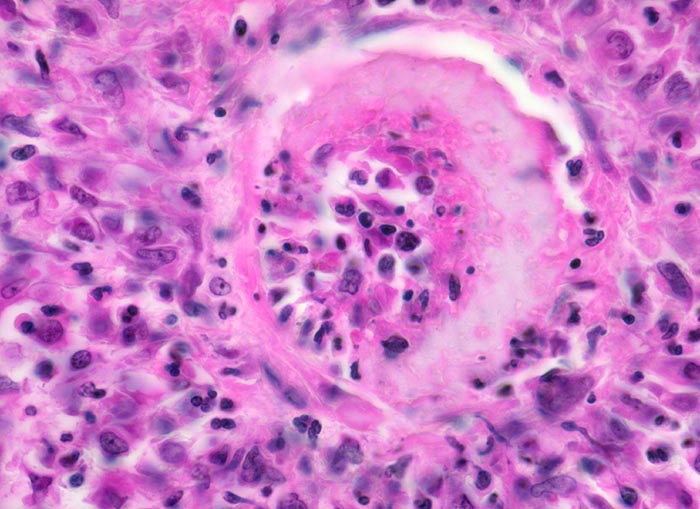

PathoPic – image database / PathoPic ID 4253 - Polyarteritis nodosa Makroform: fibrinoide Nekrose
de
Diagnose
Polyarteritis nodosa Makroform: fibrinoide Nekrose
Diagnose Gruppe
Systemerkrankung/Immunpathologie
Topographie
Niere
Topographie Gruppe
Niere, Harnwege
Beschreibung
Zusatzbefund
Makroskopischer Befund der Nieren: Vergrösserte Nieren mit Petechien und mehreren frischen, teils hämorrhagischen Infarkten.
Klinik
Seit einigen Wochen Fieber unklarer Ätiologie, Gewichtsverlust und Anämie. Im Rahmen der Abklärungen erstmals festgestellte arterielle Hypertonie. Der Patient verstirbt an einem Myokardinfarkt.
Kommentar
Bei der Polyarteriitis Makroform sind die Arteria renalis, Arteria lobaris, Arteria arcuata und Arteria interlobaris befallen. Glomeruli und Arteriolen sind nicht betroffen.
Bilder Typ
Histologie
Vergrösserung
630
Alter
64
Geschlecht
unbekannt
Datum
Ersteintrag: 06.10.2002